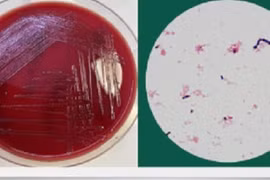
TP.HCM: Một người đàn ông nhiễm vi khuẩn liên cầu lợn

Gia Lai: Trao gần 30 triệu đồng hỗ trợ bệnh nhân nhiễm trùng huyết
(GLO)- Sáng 23-9, Hội Bảo trợ bệnh nhân nghèo tỉnh Gia Lai đã trao gần 30 triệu đồng cho gia đình bệnh nhân Phạm Văn Lượng (SN 1996, trú tại phường An Nhơn Đông, tỉnh Gia Lai).

(GLO)- Sáng 23-9, Hội Bảo trợ bệnh nhân nghèo tỉnh Gia Lai đã trao gần 30 triệu đồng cho gia đình bệnh nhân Phạm Văn Lượng (SN 1996, trú tại phường An Nhơn Đông, tỉnh Gia Lai).

| Giá cà phê | Giá trung bình | Thay đổi |
| Đắk Lắk | ||
| Lâm Đồng | ||
| Gia Lai | ||
| Đắk Nông | ||
| Hồ tiêu |




